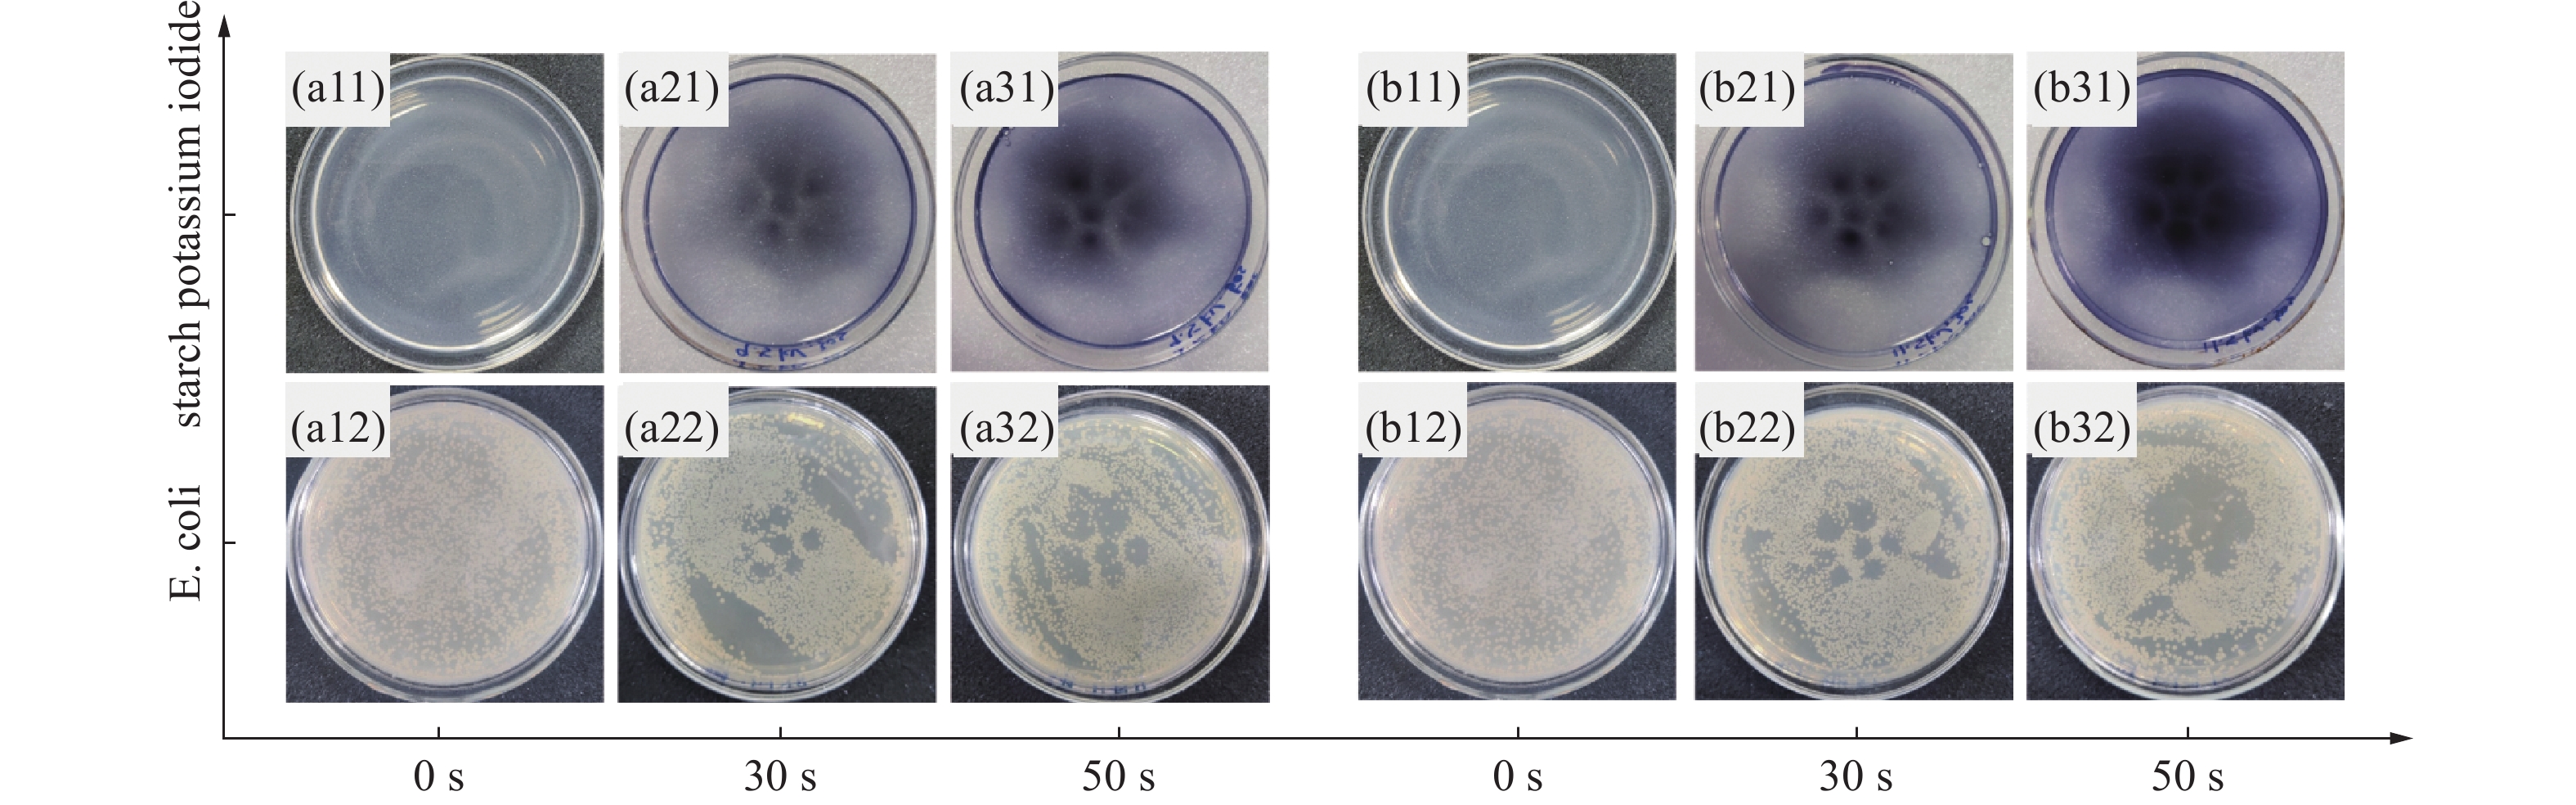

-
气体被加热或置于高频高压电场中,形成高度电离的气体云,获取巨大能量的气体云外层电子脱离原子核的束缚成为自由电子,原子核所带正电荷与自由电子所带负电荷总量相等,整体呈现出电中性状态,称之为等离子体[1,2],近年来,随着等离子体技术的不断深入研究,等离子体已经逐渐成为一门应用广泛的学科[3]。在这其中,大气压低温等离子体射流技术引起了广泛的关注。大气压等离子体射流由于具有温度低、成本低、无需真空环境以及富含活性粒子等优势,广泛应用于生物医学、纳米粒子合成以及材料表面处理[4-8]。在生物医学的应用之中,灭菌消毒是十分重要的基本技术[9]。传统灭菌消毒技术主要包括物理灭菌、化学灭菌和生物灭菌[10]。物理灭菌主要依靠高温、紫外线等方式实现灭菌,但是过高的温度极容易损坏某些医疗器械和人体组织;化学灭菌主要通过某些化学药品达到灭菌的效果,例如二溴海因、环氧乙烷等,但残留的化学药品极易对人体和环境造成无法预知的损害;生物灭菌法主要利用各种生物酶以达到消灭微生物及其排泄物的作用,但是外界条件对这种方法影响很大,并且降解率也比较低[11,12]。与以上三种传统方式相比,大气压低温等离子体射流有着温度低、效率高、无残留、处理时间短的优点[13-15]。因此利用大气压等离子体射流实现灭菌的已经成为当前的研究热点之一。
尽管拥有广泛的应用前景,等离子体射流技术还是有着局限性。首先单一等离子体射流单元难以实现大范围处理,只能在很小的区域起作用,导致应用效率低,难以大面积使用[16]。一种可行的解决方法是将多个等离子体射流单元集成在一起组成等离子体射流阵列[17,18,19]。例如,Cao等[20]就通过使用氦气一维等离子体射流阵列来处理医学手术钳,降低实验条件,取得了良好的效果。Weltmann等[21]设计了一个二维等离子体结构,通过通入氩气,使得产生的等离子体射流可以有效灭活大肠杆菌、金黄色葡萄球菌和白色念珠菌。陈竑钰等[22]研制了一套单极性微秒脉冲阵列式等离子体射流系统,在通入氦气的条件下,对枯燥芽孢杆菌进行了灭菌处理,实现了大面积灭菌处理。虽然将多个等离子体射流单元集成在一起形成阵列式可以做到大面积处理,但还是需要通入氦气等惰性气体,造成实验系统庞大,实验成本较高,大大限制了其便捷性。针对这些问题,本文设计了一个六边形自激发的大面积等离子体射流阵列装置,该装置采用自激发的方式,以空气作为载气,因此不需要通入其它惰性气体,使得所需实验条件大大降低。将钨针插入覆铜的PCB结构中作为电极,一方面整个装置实现小型化、便捷化,另一方面,有效避免实验操作过程中误触高压,实验的安全性也得到了提高。
全文HTML
-
如图1(a)所示,设计了一个正六边形的大气压自激发等离子体射流装置,其总体积约为50 mm× 50 mm× 38.5 mm。在规格为50 mm× 50 mm× 1.6 mm的两块PCB板上打出7个直径1.1 mm的圆形孔,另外一块相同尺寸的PCB板上打出7个直径6 mm的覆铜圆形孔,每块PCB板的其中6个孔都按照正六边形的6个顶点排列,且对应位置呈同心结构,另外1个孔位于正六边形的中心。PCB板6 mm直径的覆铜孔为铜环结构用以引流,将每个铜环用铜线连接,导线设置在PCB板边缘,作为接地电极。PCB板上直径1.1 mm不覆铜的圆环用来固定高压电极。对于形成射流的针电极,采用长度61 mm,直径为1.1 mm的钨针。实验装置示意图如图1所示。
整体实验装置的流程图如图2所示,其设计思路为在大气压条件下,将针电极做为高压电极和环电极做为接地电极,将其组成共轴系统,当施加高电压时,自由电子在射频场之间聚集之后,与环境中的气体分子发生碰撞,在针尖处发生尖端放电,并且通过环电极的吸引使射流长度加长,通过针-环放电电离空气产生等离子体射流。该装置不需要额外通载气,因此属于自激发等离子体。本实验中,钨针作为放电一端接高压,最下端的PCB板接地。探究射流的化学特性时,培养皿距离射流尾羽15 mm。实验输出电压及其变化由普通探头和示波器测量和显示。电路电流通过测量串联在电路中的1 kΩ测试电阻两端的电压等价得出。使用200−825 nm波长范围的四通道光谱仪对自激发等离子体射流产生的气态活性物质(通过电离空气产生的活性氧、氮粒子)进行光谱采集。
-
本文使用大肠杆菌(Escherichia coli,E.coli,ATCC25922)作为实验菌株。首先使用接种环取生长状态良好的大肠杆菌菌落接种到75 mL无菌的Luria-Bertani(LB)液体培养基中,放置在恒温震荡摇床中,于37℃活化16 h,同时以180 (rmp/min)摇动。然后,将100 μL活化一次的菌液转移到75 mL新鲜无菌的LB液体培养基中,在37℃的恒温震荡摇床上继续培养6 h,以达到细菌的最佳生长状态,并用于后续的实验。
-
本实验使用了两种琼脂板。一种是用于含有淀粉-碘化钾混合溶液的培养基。将10%碘化钾(西陇科学股份有限公司)和10%淀粉(中国上海生工公司)等比例(v/v)加入超纯水制成淀粉-碘化钾指示剂,所得溶液与50%(v/v)琼脂平板混合,其中琼脂平板由每100 mL超纯水中加入1.6 g琼脂粉配备而成。根据碘-淀粉反应,生成的活性物质亚硝酸盐(NO2−)、硝酸盐(NO3−)、臭氧(O3)、超氧根离子(O2−)、羟基(OH)、过氧化氢(H2O2)、过氧化氢离子(HOO−)等可以将淀粉-碘化钾试剂中的I−氧化为I2。I2与过量的I−反应生成I3−,然后与淀粉形成络合物,由于活性物质的存在,在酸性环境下颜色变为蓝紫色[23]。
另一种是用于灭菌实验的琼脂培养基,每毫升超纯水含有以下成分:胰蛋白胨1 g,酵母提取物0.5 g,氯化钠 0.5 g,琼脂1.6 g。配置好的琼脂培养基于高压蒸汽灭菌锅中灭菌25 min。大肠杆菌原液稀释104倍,将100 μL稀释的菌液涂布在琼脂培养基上,置于等离子体发生装置下进行灭菌处理。处理后的细菌在37℃下孵育12 h,观察不同处理条件下的灭菌效果。为防止随机误差,每个样本设置三个对照组。用同样的方法处理含有淀粉-碘化钾的琼脂平板,以研究该装置产生的活性物质分布与灭菌范围之间的关系。
1.1. 自激发射流产生装置
1.2. 细菌菌种及其培养
1.3. 实验方法
-
当施加电压小于8 kV时,自激发等离子体射流肉眼不可见,随着电压的增加开始产生射流,如图3所示。图中展示了从4.0 kV−11.0 kV的射流变化。从图中可以清晰看到随着电压的增加,等离子体射流长度也随之增大。
此外,由图1(a)可知,采用PCB作为电极结构,等离子体射流装置易于组装、便于修改的优势得到彰显,只需改变两个覆铜PCB板之间的距离,就可以达到改变电极间距的目的。同时,由图3实际的放电图像中可以看到,以PCB为电极结构的自激发等离子体射流长度基本相同,具备良好的均匀性。此外,在PCB板上覆铜,避免了传统方法的裸露电极直接与高压线连接,降低了人接触电极带来的危险。
-
本文采用钨针作为高压电极,金属钨具备导电能力强、化学性质稳定、不易氧化以及耐用性好的优势。装置采用每根针单独连接高压线的方式,因为这样得到的射流会更稳定,也会有更好的均匀性。电路中使用的镇流电阻为100 MΩ,测试电阻1 kΩ。当施加10.0 kV的直流电压时,产生的等离子体射流长度约为5 mm。射流呈子弹状,靠近针尖处呈白色,前端呈淡紫色。图4(a)为10 kV电压下的放电波形。放电波形为向上的正电压放电脉冲,频率约为506.3 kHz,脉宽约为500 ns,峰值约为0.12 V。图4(b)为放电的电流-电压特性,电压通过万用表直接测量测试电阻得到。电流在当电压加到4 kV时才可以检测得到。由图4(b)可知,电流随着输入电压的增加而增加。
-
发射光谱法是一种非介入式的高精度在线原位的检测技术,主要原理是依据各种元素的原子或离子在热激发或电激发下产生的特征辐射波长[24]。等离子所产生的活性物质对细菌灭活的过程有着十分重要的作用,本文采用发射光谱法对活性物质进行定性分析。发射光谱法的操作方法简单,对等离子体射流无干扰,并可测量暂态、稳态,可以有效反映出等离子体激发过程中所产生的原子、分子跃迁至低能态时,发射光中的活性物质及其分布情况[25]。因此通过使用光谱仪对等离子体射流产生的发射或吸收光谱进行采集和分析,确定其活性物质,对评价实际灭菌效果具有重要意义。其变化的主要过程如下[26]:
首先是气体中分子、原子离解碰撞过程中产生激发、分解、复合激发的过程,从而产生激发基团A*。
激发基团(A*)寿命小于10-8 s,且不稳定,因而又会跃迁至更低能级的激发态A**,该过程中多余能量以光的形式释放出来,从而形成光发射谱。高能级E2、低能级E1、波长为λ、普朗克常量h、光速c,其释放能
$ \Delta $ E如式(5)所示。本文采集放电电压9.5 kV,积分时间1000 ms的光谱,其波长在200−825 nm之间,图5(a)为等离子体射流发射光谱的数据。由于本文的工作气体是空气,空气中含量最高的是氮气,因此在自激发等离子体射流中所产生的光谱线主要由激发能13.06 eV的氮气分子(N2)的激发基团纳秒跃迁产生。从图5(b)所示的放大图像可以得出,自激发等离子体射流光谱中的活性物质主要集中在290−430 nm处的N2第二正带系波段,其中336.96 nm处最为突出,其主要原因是形成的低温等离子体射流电离度较低,射流通道中高能粒子与N2分子碰撞数量多、程度高、概率高,因而造成其跃迁到低能级时释放能量多,谱线强度高。如式(5)至(12)为部分N2谱线激发过程[27],式(6)至(12)则为336.9 nm处谱线产生原因。
等离子体射流产生的等离子体由OH自由基、N2、N2+和O等众多气态活性粒子组成,这是高效杀菌的条件之一。在灭菌过程中,这些活性物质与介质表面的水反应生成H2O2、NO2−和NO3−等液态活性粒子。
除此之外,通过光谱图还可以衍生出很多重要的信息,温度就是其中重要的参数。本文使用Specair软件进行拟合,算得其转动温度。具体过程如下:使用Specair软件拟合出在332−338 nm波长范围的多条N2谱线,并将拟合得到的多条N2谱线和采集到的实验光谱数据进行比较,找到与实验数据最相近的拟合数据,从而得出实验的转动温度。与拟合的温度图像进行比较,如图6所示,转动温度为300 K。
-
等离子体射流过程中会产生大量的活性物质,如O2−、O3、OH、NO3−、NO2−、H2O2等。这些活性物质分为两类。一种是寿命较短的物质,包括O2−、HOO−(寿命小于10 s[28])和OH(寿命小于100 ms[29])等;另一种是寿命较长的物质,包括O3、NO3−、NO2−和H2O2等,在等离子体处理过程中起着重要作用[30-33]。虽然这些活性物质的寿命各不相同,但都对显色反应和灭菌起着非常重要的作用,包括O2−、O3、OH、NO3−、NO2−和H2O2。前者主要作用于平面范围,后者可进一步纵向扩散[34]。但这些活性成分产物最终会溶解在液相环境中,并持续扩散,并成为引导细菌灭亡的主导因素[35]。因此,活性物质的分布与灭菌范围是分不开的。
本文针对显色反应和灭菌效果的实验,均把培养基放置在距离射流尾羽15 mm的距离下进行处理。图7显示了该装置对含有淀粉-碘化钾指示剂的琼脂板在不同实验条件下的对比图。从该对比图可以看出,当处理时间不变时,随着电压的升高,显色区域会逐步向外扩散,颜色也逐渐加深,相比较之下,中间区域颜色更深。当电压不变时,也会保持同样的规律。
图8为活性物质分布和灭菌效果对比图,从活性粒子分布区域与灭菌范围来看,淀粉碘化钾和灭菌范围分布二者是相匹配的:图8(a11~a32)显示了在9.5 kV电压下活性物质和灭菌效果图,等离子体射流处理30 s后二者作用的范围分别为268.47、225.73 mm2,二者的匹配百分比达84.08%。处理50 s后作用范围分别为359.06、351.33 mm2,二者的匹配百分比达95.85%。图8(b11~b32)所示为11.5 kV电压下活性物质和灭菌效果图,等离子体射流处理30和50 s时,两者作用的范围分别为307.34、272.43 mm2和824.88、703.36 mm2,两者的匹配百分比为别为88.74%和85.27%。在显色区域最深的地方,灭菌效果是最好的,同时二者的形状匹配度极高,并且随着处理时间的延长以及放电电压的增大,这一特性在逐步扩大,这表明该装置产生的等离子体射流阵列具有良好的杀菌效果。随着电压升高,相同处理时间下,灭菌的效果得到了明显提升。
2.1. 等离子体放电影响因素分析
2.2. 电流-电压特性
2.3. 光谱特性
2.4. 活性物质分布和灭菌
-
本文设计了一种阵列式针-环自激发等离子体射流装置。该装置不需要外接载气,通过电离空气即可产生等离子体射流。覆铜PCB板作为电极结构有助于帮助解决传统等离子体装置放电不稳定问题,实现阵列中每个单元的同步放电,同时也提高了实验装置的安全性。放电实验表明,该装置产生的等离子体射流有着良好的均匀性,同时,根据装置灭菌效果的面积与活性粒子分布范围面积做了匹配百分比的计算,计算结果表明相关实验的匹配百分比都在84%以上,这展现了该装置灭菌效果与活性粒子分布范围匹配度较高,灭菌范围所见即所得,为进一步提高灭菌范围和精准控制提供了一种新的技术手段。但是在输入电压变化的情况下,输出的等离子体仍会伴有很少的丝状放电,而且因为是在空气中直接实现射流,所以射流的长度受限,后续将会针对这些问题,展开进一步的研究,不断完善装置,以达到更好的效果。

 首页
首页 登录
登录 注册
注册





 下载:
下载: